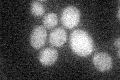
YNL008C
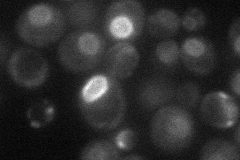
YNL008C
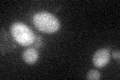
YNL008C

View description
Putative integral membrane E3 ubiquitin ligase; acts with Asi1p and Asi2p to ensure the fidelity of SPS-sensor signalling by maintaining the dormant repressed state of gene expression in the absence of inducing signals
Localization:
Intensity:
Fold change:
Significance:
-
C’ GFP library in SD
below threshold16.65 -
N' NOP1pr-GFP in SD
nuclear periphery30.9242 -
N' TEF2pr-mCherry in SD

punctate,nuclear periphery13.2181 -
N' NATIVEpr-GFP in SD

below threshold20.3134 -
N' TEF2pr-VC and Cyto-VN in SD

below threshold23.5466 -
C’ GFP library in SD+DTT
cytosol18.381.1No -
C’ GFP library in SD+H2O2

cytosol18.481.1No -
C’ GFP library in Starvation Media

cytosol14.570.87No -
C’ GFP library on the background of Pup2-DaMP

below threshold -
C’ GFP library on the background of CCT mutant

below threshold17.18511.03152No
